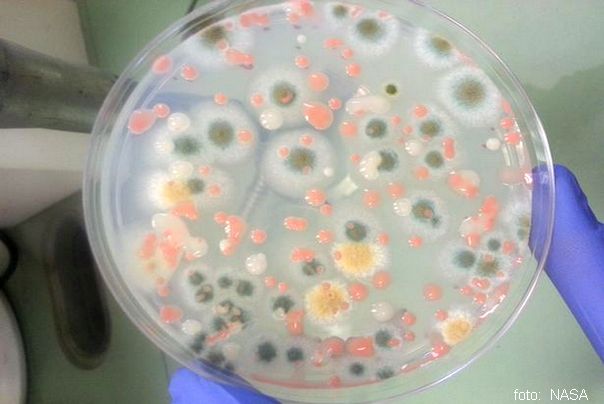
vanzemaljske bakterije

Naučnici identifikovali neotkrivenu vrstu bakterije na Međunarodnoj svemirskoj stanici

Čovečanstvo je možda konačno pronašlo „vanzemaljski život“ i to na Međunarodnoj svemirskoj stanici Naučnici NASA-e identifikovali su ranije do sada neotkrivenu vrstu bakterije koja uspeva 402km visine iznad naših glava…
na Međunarodnoj svemirskoj stanici ovo otkriće bi moglo pomoći da kao čovečanstvo stignemo do Marsa.
Naučnici NASA-e su izneli šokantnu tvrdnju nakon što su otkrili tri „prethodno neotkrivene“ vrste bakterija koje su „sposobne da se kreću“
Tri različite genetske varijante pronađene su na odvojenim lokacijama na ISS-u, uključujući specijalnu komoru za rast biljaka u kojoj istraživači pokušavaju da uzgajaju useve u uslovima nulte gravitacije prenosi Mirror
Metilobakterije, koje su u obliku štapa, mogle bi da pomognu u konačnoj kolonizaciji Marsa, prema studiji NASA objavljenoj u naučnom časopisu Frontiers In Microbiology.
Otkriće se smatra toliko važnim da Boffins sada žele da prošire stanicu kako bi uključili novu biološku laboratoriju za prikupljanje, obradu i analizu mikroba u svemiru bez potrebe da ih šalju nazad na Zemlju.
Naučnici su najmanje šest godina ispitivali letelicu – lansiranu 1998. godine, kojom upravlja pet međunarodnih svemirskih agencija i kojom upravljaju posada od sedam astronauta koja se smenjuju – radi prisustva mikroorganizama.
Naučnici NASA-e dr Nitin Kumar Sing i dr Kasturi Venkatesvaran rekli su da bi novopronađeni sojevi mogli promeniti igru u budućnosti svemirskih useva. Rekli su da je neophodno pronaći nove bakterije koje pomažu u rastu biljaka u stresnim uslovima na ekstremnim mestima sa oskudnim resursima.
Naučnici to jest istraživači smatraju da bi nove bakterije mogle pomoći u konačnoj kolonizaciji Marsa jer njihove karakteristike uključuju pomaganje vegetaciji u rastu.
Izvor: Zanimljivostidana.com
Molimo online portale (sajtove), ako kopirate orginalni clanak s našeg sajta zanimljivosti dana NAVEDITE NAS KAO IZVOR i MALO IZMENITE NASLOV.Za objavljivanje originalnih članka sa sajta na Facebook(Meta),Instagram,YouTube kontaktirajte nas za odobrenje. Hvala!
PREDLAŽEMO VAM JOŠ:



